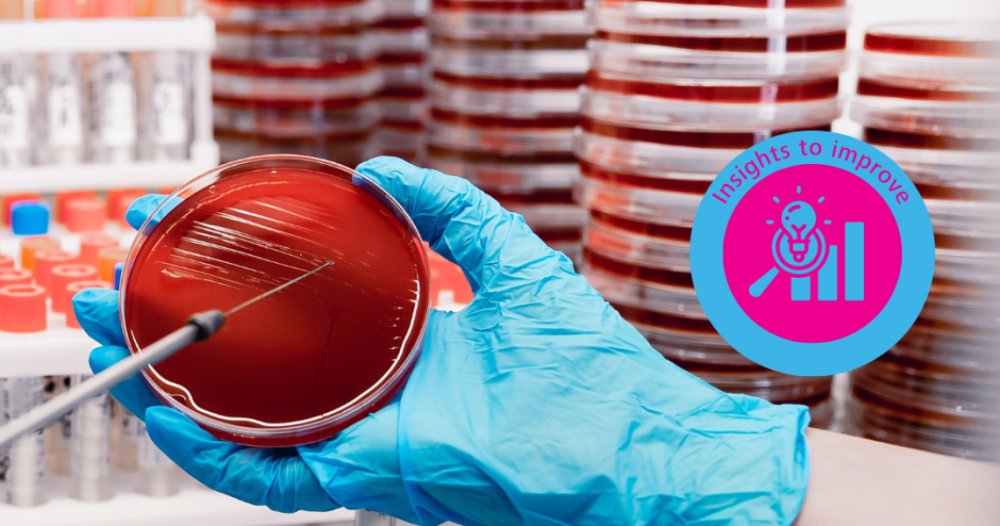

Contaminación bacteriana en el semen: alternativas para sustituir los antibióticos - Topigs Norsvin
🔗 Da clic en el blog y lee el artículo completo: Contaminación bacteriana en el semen: alternativas para sustituir los antibióticos
La contaminación bacteriana en el semen es un factor crítico que puede afectar directamente la calidad de las dosis y el desempeño reproductivo en granja.
En este artículo, exploramos cómo distintas bacterias impactan la viabilidad espermática y por qué el control no puede depender únicamente de antibióticos. Hoy, el verdadero reto está en implementar protocolos estrictos de higiene, monitoreo constante y nuevas alternativas tecnológicas que permitan reducir la resistencia antimicrobiana sin comprometer resultados.
Desde el uso de diluyentes sin antibióticos hasta soluciones innovadoras como péptidos, enzimas y bacteriófagos, la industria avanza hacia sistemas más sostenibles y eficientes.
Descubre cómo optimizar la calidad del semen y asegurar mejores resultados reproductivos con estrategias basadas en ciencia.
#Topigs #TopigsNorsvin #Porcicultura #Cerdos #ProducciónPorcina #GenéticaPorcina
Contacto:
Contacta con nosotros a través del siguiente formulario.
Un resumen semanal de las novedades de 3tres3 México
Accede y apúntate a la lista